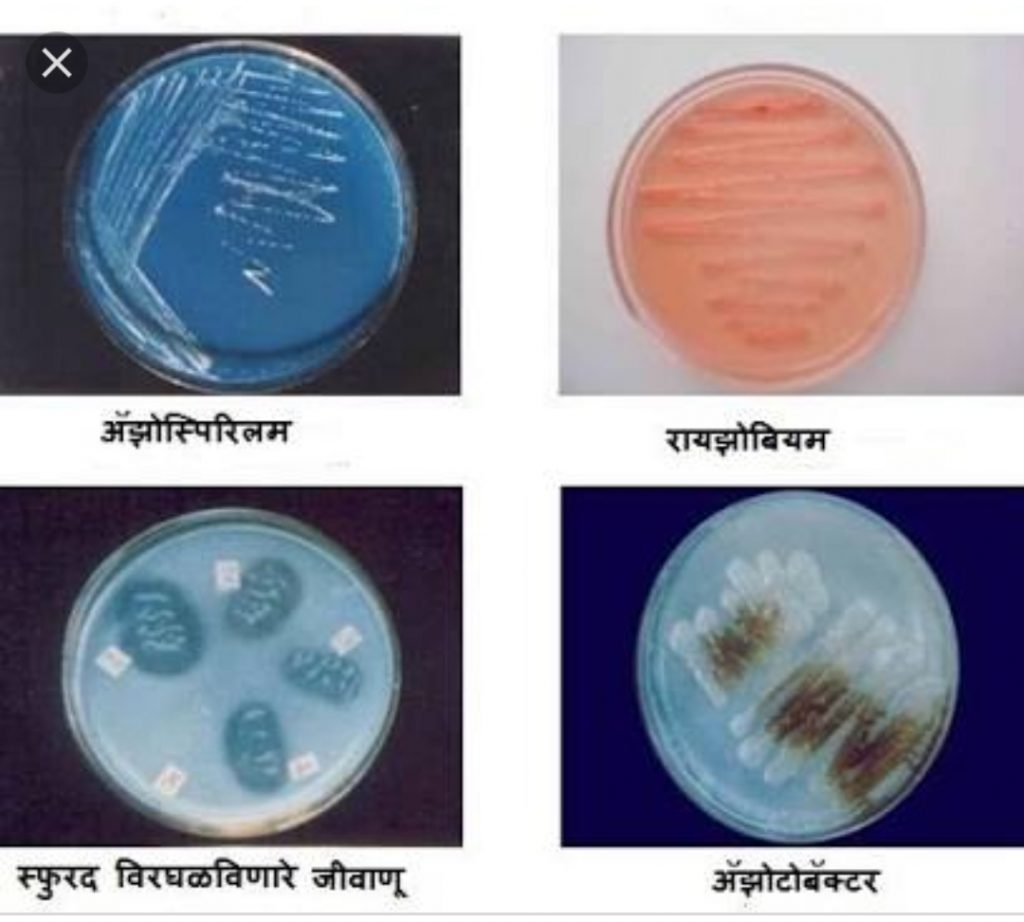

सुरक्षित व सकस अन्नासाठी जगभरात सेंद्रिय शेतीचा अवलंब केला जात आहे. वाढत्या लोकसंख्येसाठी अन्नधान्याची गरज पाहता उत्पादन वाढीसाठी रासायनिक खतांचा वापर केला जातो. परंतु रासायनिक खतांच्या अनियंत्रित वापराने शेती व पर्यावरणाची मोठी हानी होत आहे. रासायनिक खते ही महाग आहेत. त्यामुळे उत्पादन खर्चात वाढ होते. रासायनिक खते देशाबाहेरुन आयात केल्याने मोठ्या प्रमाणावर परकीय गंगाजळी वापरावी लागते. तसेच शासनास त्यावर मोठ्या प्रमाणात अनुदान देऊन रासायनिक खतांच्या किमती शेतक-यांना परवडणा-या स्तरावर आणाव्या लागतात. रासायनिक खतांच्या वापराने सेंद्रिय व जैविक खतांचा वापर कमी झाला आहे. त्यामुळे जमिनीतील सेंद्रिय पदार्थाचे प्रमाण घटले आहे. जमिनीत टाकलेली अन्नद्रव्ये व पिकांनी जमिनीतून घेतलेली अन्नद्रव्ये यामध्ये मोठी तफावत आहे.
जैविक खते
पिकास आवश्यक त्या विशिष्ट अन्नद्रव्याची उपलब्धता वाढविणा-या, मिश्रणास जैविक खत असे म्हणतात. जैविक खते ही जमिनीत नैसर्गिकरीत्या आढळणा-या जिवाणूंपासून तयार केली जातात. म्हणून जैविक खताचे जमीन व पिकावर कसलेही दुष्परिणाम होत नाहीत. जैविक खते हा शाश्वत शेतीचा मूलभूत घटक आहे.
जैविक खतांचे प्रकार
१) नत्र स्थिर करणारी जैविक खते – रायझोबियम, अझेटोबॅक्टर, अझोस्पीरीलम, असिटोबॅक्टर
२) स्फुरद विरघळविणारी जैविक खते
३) पालाश उपलब्ध करणारी जैविक खते
४) झिंक विरघळविणारी जैविक खते
४) झिंक विरघळविणारी जैविक खते
५) मायकोरायझा
६) जिवाणू संघ
स्त्रोत – कृषी विभाग महाराष्ट्र शासन
क्रमश:















जैविक खते कुठे मिळतील
सर, मी आपल्या देशाच्या सर्व शेतकर्यांन साठी गावखेती नावाची एक
याेजना तयार केली आहे, सदर योजनेचे पुस्तक प्रकाशित करने बाकी आहे या याेजना मुळे शेतकर्यांचे ३० प्रकार चे प्रश्न गावातच साेडवनु शेतकर्यांचे जिवन सुसह्य हाेन्यास मदत होणार आहे ही योजना खूप मोठी असल्याने या ठिकाणी लिहिली जावु शकत नसल्याने what’s up massage आपल्या माहिती साठी पाठवले आहे माझा माेबाईल नं ९०२२४८४८२२ असा आहे